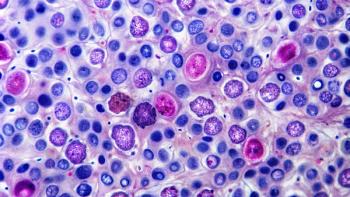

Lymphoma
Latest News

Latest Videos

Shorts
Podcasts
CME Content
More News

Umoja Biopharma's UB-VV111 gains FDA fast track designation, revolutionizing CAR T-cell therapy for relapsed lymphoma and leukemia patients.

World Lymphoma Day highlights the rising prevalence of lymphoma and innovative treatments, emphasizing the role of pharmacists in patient care.

September highlights Blood Cancer Awareness Month, focusing on education, early diagnosis, and support for multiple myeloma, lymphoma, and leukemia patients.

A patient, who formerly had previously been treated with CAR therapy for multiple myeloma, achieved remission for both multiple myeloma and lymphoma.

Julio C. Chavez, MD, MS, discusses the distinct pharmacologic profile, clinical activity, and outpatient potential of golcadomide plus rituximab in relapsed/refractory follicular lymphoma, highlighting its selective cereblon modulation, fixed-duration dosing, and promising efficacy in heavily pretreated patients.

Julio C. Chavez, MD, MS, discusses updated data from the European Hematology Association (EHA) 2025 Congress on the investigational oral CELMoD agent golcadomide (GOLCA) plus rituximab in relapsed/refractory diffuse large B-cell lymphoma (R/R DLBCL).

Andrew H. Wei, PhD, discusses phase 1b findings on the safety, pharmacokinetics, and preliminary efficacy of combining the menin inhibitor bleximenib with venetoclax and azacitidine in patients with newly diagnosed or relapsed/refractory acute myeloid leukemia (AML) harboring NPM1 mutations or KMT2A rearrangements.

Franck Morschhauser, MD, PhD, discusses the novel cereblon-dependent bifunctional degrader BMS-986458, highlighting its selective targeting of BCL6, promising early efficacy in relapsed/refractory lymphoma, favorable safety profile, and future potential in combination regimens and earlier treatment lines.

The CRL states that the STARGLO data do not provide sufficient evidence to support the second-line indication in the US patient population.

The FDA approved acalabrutinib as a frontline option for untreated mantle cell lymphoma.

Following robust progression-free survival indications in the phase 3 inMIND trial, the FDA granted approval to tafasitamab-cxix in combination with standard-of-care lenalidomide and rituximab for patients with relapsed or refractory follicular lymphoma.

Epcoritamab shows impressive long-term remission rates in relapsed large B-cell lymphoma, highlighting its potential as a key treatment option.

Glofitamab combined with GemOx shows promising survival benefits for patients with relapsed DLBCL, offering a new treatment option for those ineligible for transplants.
This CAR T-cell therapy has revolutionized the management of high-risk and relapsed or refractory disease.

Relapsed treatment has evolved with CAR T, bispecific antibodies, and immunotherapies.

The approval follows the ECHELON-3 study, which enrolled adults with relapsed or refractory large B-cell lymphoma.

MB-105 is a first-in-class CD5-targeted chimeric antigen receptor (CAR) T-cell therapy for the treatment of relapsed or refractory CD5-positive T-cell lymphoma.

Acalabrutinib with bendamustine and rituximab shows efficacy in patients with untreated mantel cell lymphoma by increasing progression-free survival in the ECHO trial.

Alison Moskowitz, MD, discusses the clinical considerations, dosing strategies, and the critical role of pharmacists in managing toxicities and tailoring treatment plans for dual-targeted therapy with ruxolitinib and duvelisib.

A ketogenic diet and its key metabolite, β-hydroxybutyrate, enhance the efficacy of CAR T-cell therapy by improving metabolic fitness, cytokine production, and cellular expansion, offering a promising, safe strategy for optimizing cancer immunotherapy.

AI-powered drug response prediction technology is revolutionizing veterinary and human oncology by enabling personalized treatment plans through live cell testing, machine learning models, and data-driven precision medicine approaches.

Lisocabtagene maraleucel chimeric antigen receptor T-cell therapy significantly enhances treatment of relapsed/refractory B-cell malignancies, offering high response rates and durable remissions.

There were 2 main types of switches, including switching to rituximab subcutaneous and switching among different intravenous rituximab treatments.

Outpatient models are emerging as feasible alternatives to traditional inpatient care, offering potential benefits such as reduced hospitalization, improved social well-being, and cost savings.

The risk of developing lymphoma remained nearly the same between patients with Crohn disease and ulcerative colitis.





































